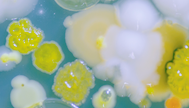
Mircobial evolution 1600x468.png

Society events and meetings
At the Society, we provide a number of high quality events and meetings throughout the year. These generally focus on a specific microbiological theme and take place as smaller more intimate meetings, allowing for informal networking and dedicated time on one subject.
Upcoming events
No records found.
Past events
Displaying 1 - 9 of 22